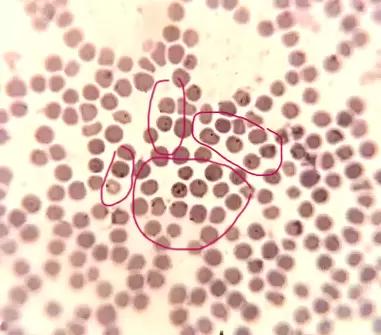

Вопросы из чатов: это пироплазмоз?
Добрый день. Подскажите пожалуйста, похоже на пироплазмоз у коровы? Вчера пришла с пастбища с температурой 41,5. Обработка от клещей была, но три недели назад, клещи у нас уже пошли.
Опубликовано: 04 апреля, 2024 в 13:30
Похожие посты
Вопросы из чатов: что с нетелью и как ее лечить?
Результаты вскрытия КРС: некроз пальца
Результаты вскрытия КРС: хроническая сердечная недостаточность

Вирусная диарея КРС: профилактика и контроль
Вопросы из чатов: как лечить корову с твердой долей вымени?


2 комментария